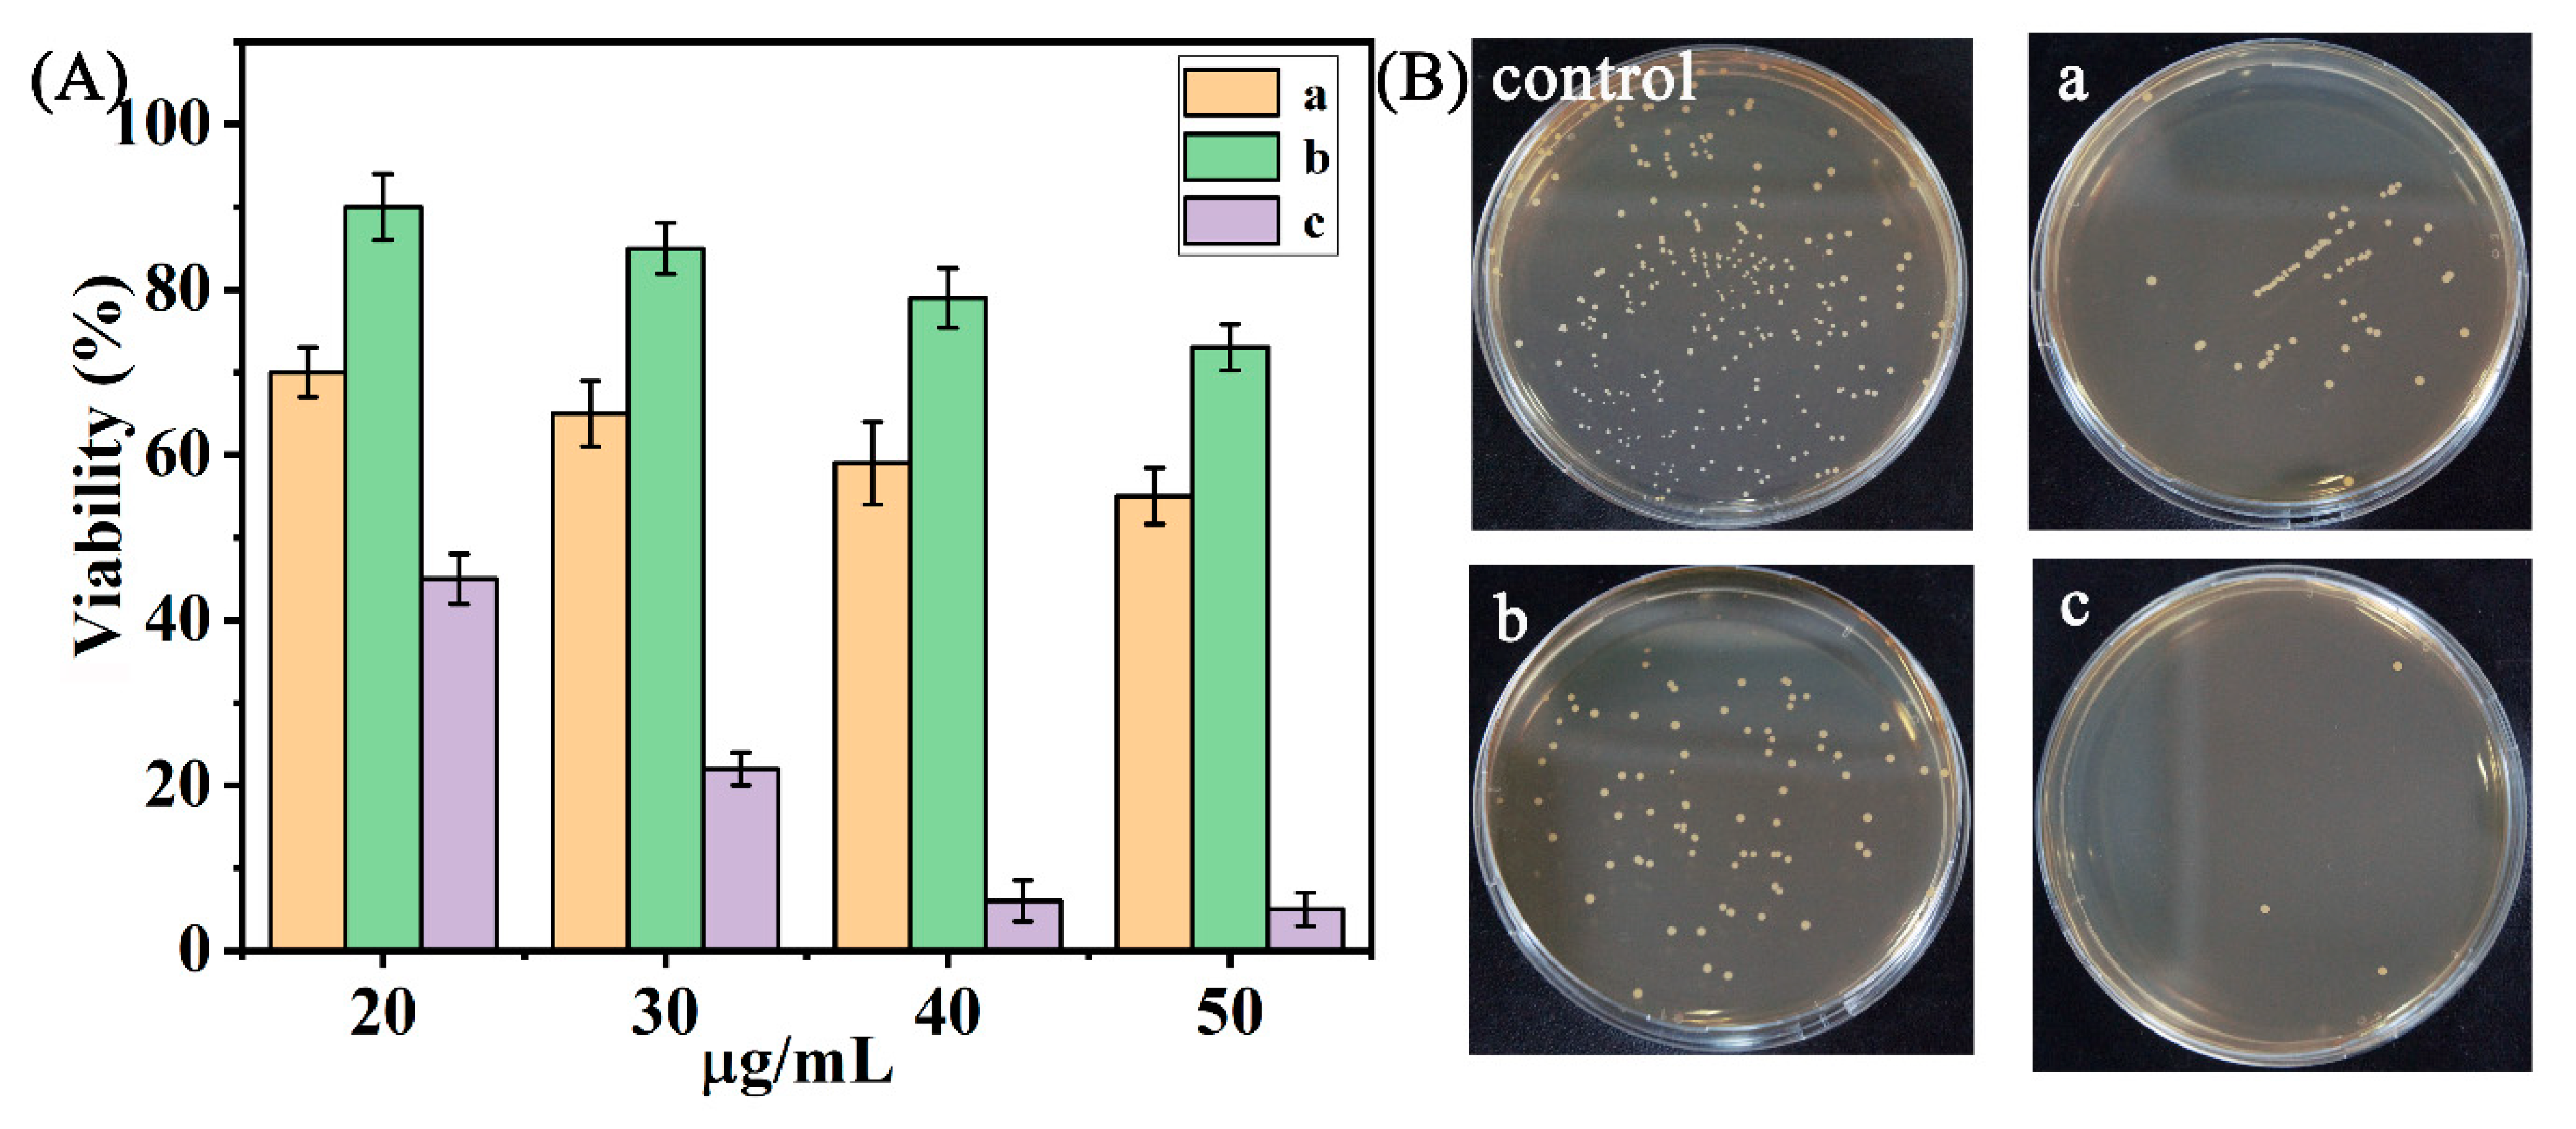
Catalysts 11 00184 g004 Catalysts 11 00184 g004

Abstract
β-NaYF4:Yb,Er,Gd fluorescent nanorods were successfully coupled to a reduced TiO2 (UCNPs@R-TiO2) nanocomposite and applied to visible-light catalytic sterilization under 980 nm near-infrared (NIR) light illumination. The UCNPs (β-NaYF4:Yb,Er,Gd) absorb the NIR light and emit red and green light. The visible light can be absorbed by the R-TiO2 (Eg = 2.8 eV) for the photocatalytic reaction. About 98.1% of Escherichia coli were effectively killed upon 12 min of NIR light irradiation at a minimum inhibitory concentration (MIC) of 40 μg/mL UCNPs@R-TiO2 nanocomposite. The bactericidal properties were further evaluated by matrix-assisted laser desorption/ionization time-of-flight mass spectrometry (MALDI-TOF MS) analysis. We found that the high bactericidal activity was due to the synergistic effect between the UCNPs and R-TiO2. Moreover, the UCNPs show excellent upconversion luminance properties, and the introduction of visible-light-absorbed R-TiO2 nanoparticles (2.8 eV) was conducive to the efficient separation and utilization of photogenerated electron-hole pairs.
1. Introduction
Bacterial infections can cause great harm to public health and have attracted considerable research attention from scientists. To date, many traditional bactericidal agents manifest a wide range of potential applications in antibacterial disinfection [1,2]. However, ordinary bactericidal agents have been shown to induce risks to the environment and encourage antibiotic resistance [3]. Contemporarily, the photocatalytic sterilization created by utilizing some reactive species produced under ultraviolet or visible light illumination has become increasingly valuable [2,4,5,6]. In short, photocatalytic nanocomposites harvest optical energy to produce positive and negative charge carriers that are involved in photoredox reactions [7,8,9]. It has been reported that TiO2 is one of the most representative and dominant photocatalysts on account of its non-toxicity and chemical stability. It, however, has a wide-band energy gap of 3.2 eV, which endows it with a high light absorption capacity within the ultraviolet (UV) light region to enhance photocatalytic efficiency with hardly any absorption within the visible region [10]; UV light and visible light account for only 5% and 45% of sunlight, respectively [10,11]. To improve the efficiency of sunlight, it would be interesting to develop TiO2-based materials that can absorb visible light. The ion doping or morphology-engineering of TiO2 nanoparticles can narrow their energy bandgap, resulting in the efficient absorption of visible light. For example, two-dimensional reduced TiO2 nanosheets with an energy bandgap of 2.86 eV have been used to efficiently inactivate bacteria under visible light irradiation [11]. Hydrothermally synthesized TiO2 nanosheets doped with N, C, and/or S also exhibit visible light absorption capacities [12,13,14,15,16]. However, ultraviolet and visible light can injure healthy tissue and display a short light penetration depth in the human body, both of which hinder their further use in in vivo antibacterial applications [17].
Recently, near-infrared (NIR) light-induced upconversion particles have been introduced to photocatalyst sterilization systems. The upconversion particles can absorb low NIR photons, convert them to higher energy photons, and emit ultraviolet or visible light [18,19]. Coupling TiO2 with upconversion particles can remarkably extend the utilization of the whole solar spectrum [20]. It has been suggested that β-NaYF4 is the most ideal upconversion matrix for the doping of different lanthanide ions, on account of its high refractive index and transparency [21]. It may act as an intermedium for transferring NIR light energy to UV-Vis light that can be absorbed by the TiO2 nanoparticles to produce oxidative holes (h+) and reductive electrons (e−). Effective e−-h+ pairs are able to react with O2, OH, and H2O in a mixed solution to generate various reactive species that are helpful for sterilization [22,23]. For instance, β-NaYF4:Yb,Er nanomaterial has been widely used in biological imaging analysis and photocatalytic applications. However, its luminous intensity is not satisfactory [24,25].
In this study, Gd-enhanced β-NaYF4:Yb,Er,Gd fluorescent nanorods with a high fluorescence intensity were coupled to reduced TiO2 nanoparticles with excellent visible light absorption abilities (UCNPs@R-TiO2 nanocomposite) using electrostatic assembly (Figure 1). As expected, the created UCNPs@R-TiO2 nanocomposite exhibits an effective photocatalytic sterilization performance against Escherichia coli (E. coli) under 980 nm NIR light illumination. The in vitro cellular cytotoxicity and antibacterial performance of the obtained UCNPs@R-TiO2 were also evaluated by MTT (3-(4,5)-dimethylthiahiazo (-z-y1)-3,5-di-phenytetrazoliumromide) assay and MALDI-TOF MS analysis, respectively.
Figure 1.
Schematic illustration of UCNPs@R-TiO2 nanocomposite for photocatalytic sterilization under 980 nm NIR light irradiation.
2. Results and Discussion
2.1. Characterization of the UCNPs@R-TiO2 Nanocomposites
The transmission electron microscopy (TEM) image shown in Figure 2A was recorded on a Tecnai G2 F20 microscope (USA) and was used to observe the crystal morphology and size of the β-NaYF4:Yb,Er,Gd fluorescent nanorods (UNCPs). The UNCPs were homo-dispersed and rod-shaped with a length of ~500 nm (Figure 2(Ba)) and a diameter of ~50 nm (Figure 2(Bb)). Moreover, the fast Fourier transform pattern indicated a (100) zone axis (Figure 2A). We found that the reduced TiO2 (R-TiO2) nanoparticles exhibited a square shape and were uniformly scattered (Figure 2C). The HRTEM (insert in Figure 2C) showed that R-TiO2 belongs to pure anatase [11]. Additionally, the TEM image in Figure 2(Da) shows that the R-TiO2 nanoparticles were successfully assembled on the UNCPs. Furthermore, we confirmed the crystal structure of the UCNPs@R-TiO2 nanocomposite and found that the average lattice spacings that can be measured are 0.521 nm and 0.352 nm (Figure 2(Db)), matching well with a (100) facet and (101) facet lattice distance for the β-NaYF4 and anatase TiO2, respectively [11,21]. From energy-dispersive X-ray spectroscopy (EDS) measurements (shown in Figure S1), the elemental composition of the UNCPs@R-TiO2 was obtained, and, as shown in the table of Figure 2(Dc), Na, Ti, Cu, Yb, F, Er, Gd, Y, and O could be detected; Cu originated from the Cu grid used for TEM measurements [26]. Taken together, these results clearly illustrate that the R-TiO2 nanoparticles were successfully assembled on the UCNPs. The FT-IR spectra of the UCNPs@R-TiO2 nanocomposite was obtained on a Nexus 670 spectrophotometer and shown in Figure S2. A strong and broad absorption band at 464 cm−1 was assigned to Ti–O and O–Ti–O flexion vibration originating from the TiO2 crystals [27,28]. The wide band of around 3435 cm−1 was attributed to the H–O stretching, which helped to enhance photocatalytic activity [27]. The band around 1557 cm−1 was attributed to the carbonyl group (−C=O−) vibration [21]. The FT-IR spectrum analysis indicates that the R-TiO2 nanoparticles were successfully assembled onto the surface of the as-synthesized UCNPs through electrostatic attraction.
Figure 2.
(A) TEM image of UCNPs, with insert showing the fast Fourier transform pattern. (B) Length (a) and diameter (b) analyses of (A). (C) TEM and HRTEM (high resolution TEM) images (inset) of R-TiO2. (D) TEM image (a), HRTEM image (b), and elemental compositions analysis (c) of UCNPs@ R-TiO2.
The XRD patterns were recorded on an X-ray diffractometer (D8 Advance, Brucker, Germany) with the Cu K radiation (λ = 0.155 nm) operating at 40 kV and 80 mA; see Figure 3A and Figure S3. Figure S3 shows that the UCNPs and R-TiO2 nanoparticles were pure hexagonal- (Joint Committee on Powder Diffraction Standards JCPDS 00-016-0334) and anatase-phase (JCPDS 01-021-1272), respectively. The sharp diffraction peaks indicate that the UCNPs and R-TiO2 nanoparticles were highly crystallized hexagonal-and anatase-structured. The XRD pattern of the UCNPs@R-TiO2 nanocomposite is shown in Figure 3A. And the XRD pattern analysis confirmed that the UCNPs@R-TiO2 nanocomposite had a high degree of crystallization. The XRD pattern further showed that the UCNP nanorods were in a pure hexagonal phase (JCPDS 00-016-0334), which has been previously shown to have a higher luminous efficiency than the cubic phase NaYF4 [29]. The distinct peaks at 25.3° of the prepared R-TiO2 nanoparticles are likely ascribed to the (101) facet of the anatase TiO2 when compared to the JCPDS 01-021-1272 database, indicating that the R-TiO2 nanoparticles were present on the surface of the UCNP fluorescent nanorods by a form of substitutional doping. Compared to the peak locations of pure hexagonal and anatase phase, we observed that all of the diffraction peaks of the UCNPs@R-TiO2 nanocomposite shifted to lower diffraction angles due to an expansion in unit-cell volume as a result of the partial substitution of Ti4+ (65 pm) by the larger Y3+ (104 pm) in the lattice [26].
Figure 3.
(A) X-ray powder diffraction (XRD) patterns of UCNPs@R-TiO2 and the standard hexagonal phase (JCPDS 00-016-0334) and anatase phase (JCPDS 01-021-1272). (B) The upconversion luminescence (UCL) spectrum of the UCNPs (a) and UCNPs@R-TiO2 (b). (C) The UV-Vis absorption spectrum of TiO2 (a) and R-TiO2 (b), with insert showing the corresponding bandgap determined by Tauc plot. (D) The zeta potential of UCNPs (a), R-TiO2 (b), and UCNPs@R-TiO2 (c).
As shown in Figure S4, the upconversion luminescence (UCL) intensity of the Gd-doped β-NaYF4:Yb,Er (UCNPs) fluorescent nanorods recorded on a Hitachi F-7000 spectrometer was higher than that of the β-NaYF4:Yb,Er fluorescent nanorods, which was attributed to the Gd dopant [21,30]. The UCL spectra of the UCNP nanorods and the UCNPs@R-TiO2 nanocomposite were analyzed and shown in Figure 3(Ba,b). We found that, under 980 nm irradiation, the UCNP nanorods emit intense UCL emissions at 523, 542, and 658 nm, which were assigned to the 2H11/2–4I15/2, 4S3/2–4I15/2, and 4F9/2–4I15/2 transitions of Er3+ (Figure 1), respectively [21]. By contrast, the UCNPs@R-TiO2 exhibited a drastic reduction to the UCL intensity because of the energy transfer from UCNPs to R-TiO2 [20]. The absorption spectrum in the UV-Vis range (Figure 3C) was recorded on a UV-visible Cary 300 spectrophotometer and indicated that the R-TiO2 (Figure 3(Ca)) possesses a higher absorption in the visible light region than pure anatase TiO2 (Figure 3(Cb)), which was caused by the oxygen vacancies and lower bandgap of the R-TiO2 (2.8 eV) than that of TiO2 (3.2 eV) (inset in Figure 3C and Equation (S1)) [10]. The oxygen vacancies and low bandgap of the R-TiO2, which arose from the dopant of Ti3+ under an argon atmosphere, are helpful to enhance the absorption of visible light [10,11]. In addition, we observed that the emission peaks of UCNPs can match the enhanced visible light absorption of the R-TiO2 nanoparticles (see the dotted boxes in Figure 3C), based on the UV-Vis absorption spectrum data (Figure 3C). We also found that the zeta potentials of the UCNP nanorods (Figure 3(Da)) and R-TiO2 nanoparticles (Figure 3(Db)) were negative and positive, respectively, indicating that R-TiO2 can be coupled to the surface of UCNP nanorods in a solution by electrostatic attraction. As a result, the UCNPs@R-TiO2 composites possessed a positive zeta potential (Figure 3(Dc)) that helps its binding to the negatively charged surface of E.coli bacteria [31].
2.2. Antibacterial Performance
The plate-counting bacteria colonies of E. coil were used to evaluate the bacteriostatic ability of UCNPs@R-TiO2 composites under 980 nm light irradiation (1 W). Under the different preparation conditions (Table S1), the highest antibacterial efficiency (98.1%) was achieved for the UCNPs@R-TiO2 (180 °C, 20 h) composites. The low reaction temperature (180 °C) was unfavorable to the crystal growth of R-TiO2, and the high reaction temperature (300 °C) caused the agglomeration of R-TiO2, which was not good for photocatalytic reactions [11,31]. Simultaneously, the high crystallinity of R-TiO2 was achieved at the optimal reaction time (20 h) [11]. The highest antibacterial efficiency (98.7%) was also achieved on the UCNPs@R-TiO2 (40%) composites among the different mass ratios of R-TiO2 and UCNPs (Figure S5). Consequently, the optimal UCNPs@R-TiO2 (30%, 180 °C, 20 h) composites were used for further research. As shown in Figure 4A, the bacterial photoinactivation effect was suitably correlated with the dosage of nanomaterials and the UCNPs@R-TiO2 nanocomposite, resulting in the highest bactericidal effect (97.3%) at the concentration of 50 μg/mL. Interestingly, we further found that both the UCNPs (Figure 4(Ba)) and R-TiO2 (Figure 4(Bb)) were capable of killing E. coil colonies on the agar plate under 980 nm laser irradiation for 12 min when compared to the saline control (Figure 4B). Strikingly, the UCNPs@R-TiO2 nanocomposite (Figure 4(Bc) and Figure S6) treatment eliminated about 98.1% of E. coil colonies on the plate, reflecting its enhanced bactericidal activity. Simultaneously, the bactericidal performance of the optimized UCNPs@R-TiO2 nanocomposite was compared to the previously reported works (Table S2). We also found that the UCNPs@R-TiO2 nanocomposite had the best bactericidal effect among these antibacterial agents.
Figure 4.
(A) E. coli viability under all different sample concentrations and (B) photographs of agar plates of E. coli incubated with 40 μg/mL of UCNPs (a), R-TiO2 (b), and UCNPs@R-TiO2 nanocomposite (c) using a 980 nm laser (1 W, 12 min).
The sterilization of these three materials under the same condition was also investigated via matrix-assisted laser desorption/ionization time-of-flight mass spectrometry (MALDI-TOF MS) analysis. As shown in Figure 5a, there were distinct characteristic peaks (m/z = 4331, 5060, 6220, 7250, 9190, 9519) of E. coli K12 [32,33,34] present in our analysis, indicating the massive survival of E. coli K12. However, the number of peaks was dramatically decreased upon adding either the UCNP nanorods (Figure 5b) or R-TiO2 nanoparticles (Figure 5c), indicating that some of the bacteria were killed. Importantly, there were no characteristic peaks detected between the 4000 to 14,000 Da region after the treatment of the UCNPs@R-TiO2 composites, indicating that the E. coli K12 was nearly entirely killed. All these data demonstrate that the UCNPs@R-TiO2 nanocomposites possessed a highly effective bactericidal ability under the 980 nm NIR illumination.
Figure 5.
MALDI-TOF MS analysis of E. coli without (a) and with R-TiO2 (b), UCNPs (c), and UCNPs@R-TiO2 composites (d) under 980 nm NIR light irradiation for 20 min (40 μg/mL). The red band is the characteristic peak of E. coli at m/z = 7250.
2.3. Cytotoxicity Assessment
We evaluated the potential cytotoxicity to cells (HEK 293) of the as-prepared nanocomposites via MTT assay. There was about 80%, 87%, and 98% viability of HEK293 cells upon the treatment of the UCNPs, R-TiO2, and UCNPs@R-TiO2 materials at a concentration of 12 μg/mL, indicating low cytotoxicity to mammalian cells (Figure 6). It was noted that the cell viability was largely decreased to around 68% when the UCNP concentration was up to 50 μg/mL. By contrast, R-TiO2 showed almost no toxicity to HEK 293 cells, because the HEK 293 cells still manifested a high survival rate (more than 91%) even under a high concentration (100 μg/mL) condition. Notably, the cell viability of the UCNPs@R-TiO2 treatment was improved, possibly due to the low toxicity of R-TiO2. About 80% of cells survived under a high concentration (40 μg/mL) of UCNPs@R-TiO2 incubation, demonstrating its potential for bactericide material application [35].
Figure 6.
Cytotoxicity of UCNPs (a), R-TiO2 (b), and UCNPs@R-TiO2 nanocomposite (c) in HEK 293 cells.
2.4. Antibacterial Mechanism
Figure 7 depicts the possible 980 nm NIR light-driven antibacterial mechanism of the UCNPs@R-TiO2 nanocomposites. After the 980 nm NIR light irradiation, the 2F7/2 state electrons of Yb3+ would be promoted into the 2F5/2 excited state band of Yb3+, then the Yb3+ 2F5/2 state would be relaxed by energy transfer to a neighboring Er3+ ion. The energy promotes the valence band (4I15/2) electrons of Er3+ into the excited state band (2H11/2, 4S3/2, or 4F9/2). The electrons in the states H, S, or F in Er3+ are unstable and would be relaxed to the 4I15/2 state by releasing energy, emitting at 523 nm, 542 nm, and 658 nm, respectively [21,35,36]. The visible light energy would be further absorbed by the valence band electrons of neighboring R-TiO2 nanoparticles. The high energy valence electrons would jump into the stable conduction band, producing electron-hole pairs.
Figure 7.
Photoluminescence spectra of UCNPs (a), R-TiO2 (b), and UCNPs@R-TiO2 nanocomposite (c), respectively, measured under 980 nm NIR illumination for 20 min.
The visible light (red and green light) emitted by UCNPs is absorbed by the R-TiO2 to produce strongly reductive electrons (e−) and oxidative holes (h+). The valid h+/e− pairs afterwards could react with H2O and O2 in an aqueous solution (Equations (1)–(7)) to produce reactive species. As it is known, the generated hydroxyl radical (·OH) species can be used as a strong oxidizer for the non-selective killing of bacteria [37]. The amount of ·OH is detected by the fluorescent intensity of 2-hydroxyterephthalic acid (λ = 420 nm) which is a product of the reaction of ·OH with terephthalic acid [38]. As shown in Figure 7, the UCNPs@R-TiO2 nanocomposite has the highest fluorescent intensity among these materials, indicating the amount of OH that was generated. These results show that the visible light emitted by UCNPs can be effectively absorbed by R-TiO2 nanoparticles. The UCNPs@R-TiO2 composites possess excellent photocatalytic performance and the specific process of the NIR photocatalytic sterilization of E. coli is summarized using the following reactions:
UNCPs + NIR light → Visible light,
R-TiO2 + Visible light → h+ + e−
O2 + e− → ·O2−,
2·O2− + 2H+ → H2O2 + O2,
·O2− + H2O2 → ·OH + OH− + O2,
H2O + h+ → ·OH + H+,
·OH + E. coli → Inactivated E. coli.
3. Experimental Designs
3.1. Reagents and Materials
All of the chemical reagents—at analytical grade, unless otherwise noted—were used without further purification. Ytterbium(III) chloride hexahydrate (YbCl3·6H2O), Yttrium(III) chloride hexahydrate (YCl3·6H2O), Gadolinium(III) chloride (GdCl3·6H2O), and Erbium(III) chloride (ErCl3) were purchased from Alfa Aesar (Shanghai, China). Titanium isopropoxide, sodium hydroxide (NaOH, 96%), oleic acid (OA), sodium citrate, hydrofluoric acid, acetonitrile, ethanol, and chloroform of analytical grade were purchased from Sinopharm Chemical Reagent Co., Ltd. from Shanghai, China. NH4F and Thiazolyl Blue Tetrazolium Bromide (MTT) were obtained from Aladdin (Hang Kong, China) and Bomei Biotechnology (Hefei, China), respectively. Ultrapure water (18.2 MΩ·cm, Mili-Q, Millipore, Burlington, MA, USA) was used throughout the experiment.
3.2. Preparation of β-NaYF4:Yb,Er,Gd (60, 18, 2, 20 mol%) Fluorescent Nanorods
The preparation of β-NaYF4:Yb,Er,Gd (60, 18, 2, 20 mol%) highly fluorescent nanorods (UCNPs) is summarized as follows [21,39]: Firstly, a mixed solution with 10 mL of ethanol, 3 mL of deionized water, and 0.6 g of NaOH was obtained. A total of 10 mL of oleic acid was then dropped in the above mixture under vigorous stirring. The stirring was continued for 20 min; the obtained mixture was named A solution. Moreover, 145.6 mg of YCl3·6H2O, 59.47 mg of GdCl3·6H2O, 4.38 mg of ErCl3, and 55.8 mg of YbCl3·6H2O were dissolved in 4 mL of deionized water; this mixture was named B solution. Then, B solution was slowly dropped into the A solution under vigorous stirring. After 10 min, 2.0 mL of NH4F (2 M) solution was added to the above mixture dropwise. Finally, a milky colloidal solution was produced. The obtained solution was encapsulated in a 50 mL autoclave flask and heated to 180 °C at a heating rate of 3 °C/min, then it was kept at 200 °C for 2 h. The prepared UCNPs were collected and washed with ethanol and ultrapure water, respectively.
3.3. Synthesis of UCNPs@R-TiO2 Nanocomposite
UCNPs@R-TiO2 were prepared as follows [11,20,40]. Firstly, the R-TiO2 nanoparticles (TiO2−x) were prepared as follows: 4 μL of titanium isopropoxide was dropped into a solution containing 1.2 mL of HF and 20 mL of isopropanol. After the obtained mixture was stirred for 10 min under an argon atmosphere, 5 μL of TiCl3 solution was added to it [11]. Then, 20 mg of UCNPs were also added to the obtained mixture under an ultrasonic bath and the mixture solution continued to sonicate for 30 min under an argon atmosphere. The obtained mixture was then encapsulated into a 50 mL autoclave flask, heated to 180 °C at a heating rate of 3 °C/min, and kept at 180 °C for 20 h under an argon atmosphere. The produced UCNPs@R-TiO2 (40%) nanocomposite was collected and washed, first with ethanol and then with ultrapure water. It was then dried at 60 °C for 10 h in a vacuum environment. The R-TiO2 nanoparticles and UCNPs@R-TiO2 nanocomposites with different mass ratios were prepared according to the above method by changing the amount of UCNPs.
3.4. Vitro Cell Viability Assay
A standard MTT assay was used to assess the cytotoxicity of the UCNPs, R-TiO2, and UCNPs@R-TiO2. Human Embryonic Kidney 293 cells (HEK293) were selected for the assay. The temperature of the whole incubation process was controlled at 37 °C. The HEK293 cells present in a 96-well plate (with 10,000 cells per well) were first cultured for 12 h. After that, the different calculated concentrations of UCNPs, R-TiO2, and UCNPs@R-TiO2 nanomaterials were added to the above plate and the mixture was further incubated for 24 h. Afterwards, 100 μL of MTT solution was added to each well. After incubation for 2 h, the sediment was retained. Then, 100 μL of DMSO (dimethyl sulfoxide) was added into each sample mentioned above and the mixture was shaken for 20 min. The absorbance at 595 nm detected by a microplate reader was used to calculate the cell viability rate.
3.5. Bacteria (E. coli K12) Culture and Preparation
E. coli K12 were inoculated into the Luria-Bertani broth and shaken (300 rpm) constantly in an incubator shaker at 37 °C. After overnight incubation, the E. coli K12 suspensions (8 mL) were centrifuged (8000 rpm) for 2 min and the sediments were retained. The obtained precipitates were resuspended by adding 6 mL of sterile normal saline. By measuring the optical density (OD) value at 600 nm, the bacterium liquid concentration was adjusted to a proper level for after use. Different colonies were distributed on LB plates and incubated at 37 °C overnight. The relevant colony-forming units (CFU) were calculated to obtain the number of bacteria per milliliter.
3.6. Antibacterial Properties
The Gram-negative bacterium E. coli K-12 was used to investigate the in vitro antibacterial abilities of the UCNPs, R-TiO2, and UCNPs@R-TiO2. An amount of 900 μL of E. coli suspension (~106 CFU/mL) and 100 μL of these nanomaterials at different concentrations were mixed. The resulting concentrations were 20, 30, 40, and 50 μg/mL, respectively. After incubation at 37 °C for 2 h, the obtained bacterial suspension was diluted by a factor of 103. The resulting bacterial samples were irradiated for 20 min by a 980 nm NIR light (1 W). Afterwards, 100 µL of the above suspension was spread on the Luria-Bertani medium and hatched at 37 °C for 16 h. In the end, the antibacterial abilities were assessed on the LB agar plates using the colony counting method. Simultaneously, instead of the added nanocomposites, an isotonic saline solution was added into the E. coli suspension as a blank control.
3.7. MALDI-TOF MS Analysis
The characterization changes of E. coli K12 bacterial strains were analyzed using a MALDI-TOF MS [11,41,42,43]. Firstly, 300 μL of ultrapure water and 900 μL of ethanol were mixed, and then 20 mg of the E. coli sample was added into the mixture under mild shaking. The sediment was retained after centrifuging (13,000 rpm) for 3 min. Subsequently, 50 μL of CH3CN (acetonitrile) and 50 μL of 70% HCOOH (formic acid) were added. The mixture was centrifuged at 13,000 rpm for 2 min again. The above mixture (0.5 μL) and a DHB matrix solution (2,5-dihydroxybenzoic acid solution, 0.5 μL) were dropped on a plate and allowed to dry. The experiments of the MALDI-TOF MS were performed on an UltrafleXtreme TOF/TOF operating system equipped with a 355 nm N2 laser. The operating conditions were as follows: positive ion mode, mass range (5–20 kDa), and acceleration voltage (20 kV).
4. Conclusions
The UCNPs@R-TiO2 nanocomposite, an effective antibacterial material, was prepared with the electrostatic assembly strategy. The reduced TiO2 nanoparticles with a bandgap of 2.8 eV and the ability to absorb visible light were successfully assembled onto the surface of Gd-enhanced β-NaYF4:Yb,Er fluorescent nanorods. The UCNPs@R-TiO2 composite with an MIC of 40 μg/mL can kill more than 98.1% of E. coli within 12 min under 980 nm NIR light irradiation (1 W). The good antibacterial properties are mostly attributed to the efficient light energy transfer from UCNPs to R-TiO2 nanoparticles. The low-toxicicity UCNPs@R-TiO2 nanocomposite shows great potential for creating efficient NIR-responsive photocatalysts.
Supplementary Materials
The following are available online at https://www.mdpi.com/2073-4344/11/2/184/s1: Figures S1–S6: EDX, FT-IR, XRD, UCL and Antibacterial efficiency analysis of the prepared nanomaterials, Table S1: Antibacterial efficiency of UCNPs@R-TiO2 nanocomposite under different preparation conditions, Table S2: Comparison of the performance of UCNPs@R-TiO2 photocatalytic sterilization system with that of some antibacterial agents.
Author Contributions
H.Z.: the acquisition and analysis of data for the work; Drafting the work; Final approval of the version to be published; Agreement to be accountable for all aspects of the work. F.H.: the conception or design of the work; revising the work; Final approval of the version to be published; Agreement to be accountable for all aspects of the work. All authors have read and agreed to the published version of the manuscript.
Funding
This research funded by National Natural Science Foundation of China, grant number 21275042.
Institutional Review Board Statement
The study was conducted and approved by the Ethics Committee of University of South China (SYXK(湘)2020-0002 and January, 2020).
Informed Consent Statement
Informed consent was obtained from all subjects involved in the study.
Data Availability Statement
Data sharing not applicable.
Conflicts of Interest
There are no conflict of interest to declare.
References
- Qian, Y.; Qi, F.; Chen, Q.; Zhang, Q.; Qiao, Z.; Zhang, S.; Wei, T.; Yu, Q.; Yu, S.; Mao, Z.; et al. Surface Modified with a Host Defense Peptide-Mimicking β-Peptide Polymer Kills Bacteria on Contact with High Efficacy. ACS Appl. Mater. Interfaces 2018, 10, 15395–15400. [Google Scholar] [CrossRef] [PubMed]
- Cruz, J.; Flórez, J.; Torres, R.; Urquiza, M.; Gutiérrez, J.A.; Guzmán, F.; Ortiz, C.C. Antimicrobial activity of a new synthetic peptide loaded in polylactic acid or poly (lac-tic-co-glycolic) acid nanoparticles against Pseudomonas aeruginosa, Escherichia coli O157:H7 and methicillin resistant Staphylococcus aureus (MRSA). Nanotechnology 2017, 28, 135102–135110. [Google Scholar] [CrossRef] [PubMed]
- Chait, R.; Craney, A.; Kishony, R. Antibiotic interactions that select against resistance. Nat. Cell Biol. 2007, 446, 668–671. [Google Scholar] [CrossRef]
- Yin, Q.; Tan, L.; Lang, Q.; Ke, X.; Bai, L.; Guo, K.; Qiao, R.; Bai, S. Plasmonic molybdenum oxide nanosheets supported silver nanocubes for enhanced near-infrared antibacterial activity: Synergism of photothermal effect, silver release and photocatalytic reactions. Appl. Catal. B Environ. 2018, 224, 671–680. [Google Scholar] [CrossRef]
- Ao, Z.; Sun, H.; Li, G.; Zhao, H.; Wong, P.K. Differences in photoelectrocatalytic inactivation processes between E. coli and its isogenic single gene knockoff mutants: Destruction of membrane framework or associated proteins? Appl. Catal. B Environ. 2016, 188, 360–366. [Google Scholar] [CrossRef]
- Song, J.; Yu, J.; Sun, G.; Si, Y.; Ding, B. Visible-light-driven, hierarchically heterostructured, and flexible silver/bismuth oxyiodide/titania nanofibrous membranes for highly efficient water disinfection. J. Colloid Interface Sci. 2019, 555, 636–646. [Google Scholar] [CrossRef]
- Liu, Y.; Luo, X.; Zhou, C.; Du, S.; Zhen, D.; Chen, B.; Li, J.; Wu, Q.; Iru, Y.; Chen, D. A modulated electronic state strategy designed to integrate active HER and OER components as hy-brid heterostructures for efficient overall water splitting. Appl. Catal. B-Environ. 2019, 260, 118197–118210. [Google Scholar] [CrossRef]
- Zhen, D.; Shi, S.; Gao, C.; Kang, Q.; Xiao, X.; Grimes, C.A.; Cai, Q. Bi, Fe and Ti ternary co-doped ZrO2 nanocomposites as a mass spectrometry matrix for the deter-mination of bisphenol A and tetrabromobisphenol A in tea. Microchim. Acta 2020, 187, 582–593. [Google Scholar] [CrossRef]
- Nie, Y.C.; Yu, F.; Wang, L.C.; Xing, Q.J.; Liu, X.; Pei, Y.; Zou, J.P.; Dai, W.L.; Li, Y.; Suib, S.L. Photocatalytic degradation of organic pollutants coupled with simultaneous photocatalytic H2 evolution over graphene quantum dots/Mn-N-TiO2/g-C3N4 composite catalysts: Performance and mechanism. Appl. Catal. B-Environ. 2018, 227, 312–321. [Google Scholar] [CrossRef]
- Sorcar, S.; Hwang, Y.; Grimes, C.A.; In, S.-I. Highly enhanced and stable activity of defect-induced titania nanoparticles for solar light-driven CO2 reduction into CH. Mater. Today 2017, 20, 507–515. [Google Scholar] [CrossRef]
- Zhen, D.; Liu, Y.A.; Grimes, C.; Cai, Q. Reduced titania nanosheets as an effective visible-light germicide. Nanotechnology 2019, 30, 405602. [Google Scholar] [CrossRef] [PubMed]
- Liu, G.; Yang, H.G.; Wang, X.; Cheng, L.; Pan, J.; Lu, G.Q.; Cheng, H.M. Visible light responsive nitrogen doped anatase TiO2 sheets with dominant {001} facets de-rived from TiN. J. Am. Chem. Soc. 2009, 131, 12868–12869. [Google Scholar] [CrossRef]
- Xiang, Q.; Yu, J.; Wang, W.; Jaroniec, M. Nitrogen selfdoped nanosized TiO2 sheets with exposed {001} facets for enhanced visible-light photocatalytic activity. Chem. Commun. 2011, 47, 6906–6908. [Google Scholar] [CrossRef] [PubMed]
- Yu, J.; Dai, G.; Xiang, Q.; Jaroniec, M. Fabrication and enhanced visible-light photocatalytic activity of carbon selfdoped TiO2 sheets with exposed {001} facets. J. Mater. Chem. 2011, 21, 1049–1057. [Google Scholar] [CrossRef]
- Zhang, J.; Wu, Y.; Xing, M.; Leghari, S.A.K.; Sajjad, S. Development of modified N doped TiO2 photocatalyst with metals, nonmetals and metal oxides. Energy Environ. Sci. 2010, 3, 715–726. [Google Scholar] [CrossRef]
- Miyauchi, M.; Takashio, M.; Tobimatsu, H. Photocatalytic Activity of SrTiO3 Codoped with Nitrogen and Lanthanum under Visible Light Illumination. Langmuir 2004, 20, 232–236. [Google Scholar] [CrossRef] [PubMed]
- Chang, J.; Ning, Y.; Wu, S.; Niu, W.; Zhang, S. Effectively Utilizing NIR Light Using Direct Electron Injection from Up-Conversion Nanoparticles to the TiO2 Photoanode in Dye-Sensitized Solar Cells. Adv. Funct. Mater. 2013, 23, 5910–5915. [Google Scholar] [CrossRef]
- Wang, F.; Deng, R.; Wang, J.; Wang, Q.; Han, Y.; Zhu, H.; Chen, X.; Liu, X. Tuning upconversion through energy migration in core–shell nanoparticles. Nat. Mater. 2011, 10, 968–973. [Google Scholar] [CrossRef]
- Sun, M.; Dong, H.; Dougherty, A.W.; Lu, Q.; Peng, D.; Wong, W.-T.; Huang, B.; Sun, L.-D.; Yan, C. Nanophotonic energy storage in upconversion nanoparticles. Nano Energy 2019, 56, 473–481. [Google Scholar] [CrossRef]
- Tang, Y.; Di, W.; Zhai, X.; Yang, R.; Qin, W. NIR-Responsive Photocatalytic Activity and Mechanism of NaYF4:Yb,Tm@TiO2 Core–Shell Nanoparticles. ACS Catal. 2013, 3, 405–412. [Google Scholar] [CrossRef]
- Huang, X.; Wang, L.; Zhang, X.; Yin, X.; Bin, N.; Zhong, F.; Liu, Y.; Cai, Q. Dye-assembled nanocomposites for rapid upconversion luminescence sensing of Cu2+. Sens. Actuators B Chem. 2017, 248, 1–8. [Google Scholar] [CrossRef]
- Zhen, D.; Gao, C.; Yang, D.; Zhu, X.; Grimes, C.A.; Liu, Y.; Cai, Q. Blue Ti3+ self-doped TiO2 nanosheets with rich {001} facets for photocatalytic performance. New J. Chem. 2019, 43, 5759–5765. [Google Scholar] [CrossRef]
- Sun, J.; Song, L.; Fan, Y.; Tian, L.; Luan, S.; Niu, S.; Ren, L.; Ming, W.; Zhao, J. Synergistic Photodynamic and Photothermal Antibacterial Nanocomposite Membrane Triggered by Single NIR Light Source. ACS Appl. Mater. Interfaces 2019, 11, 26581–26589. [Google Scholar] [CrossRef]
- Chen, G.; Qiu, H.; Prasad, P.; Chen, X. Upconversion Nanoparticles: Design, Nanochemistry, and Applications in Theranostics. Chem. Rev. 2014, 114, 5161–5214. [Google Scholar] [CrossRef] [PubMed]
- González-Béjar, M.; Liras, M.; Francés-Soriano, L.; Voliani, V.; Herranz-Pérez, V.; Duran-Moreno, M.; Garciaverdugo, J.M.; Alarcon, E.I.; Scaiano, J.C.; Pérez-Prieto, J. NIR excitation of upconversion nanohybrids containing a surface grafted Bodipy induces oxygen-mediated cancer cell death. J. Mater. Chem. B 2014, 2, 4554–4563. [Google Scholar] [CrossRef] [PubMed]
- Zhou, Q.; Li, C.; Chen, P.; Cai, Q. Preparation of Bi0.15Fe0.15TiO2 Nanocomposites for the Highly Selective Enrichment of Phospho-peptides. Anal. Chem. 2018, 90, 12414–12421. [Google Scholar]
- Li, J.L.; Zhen, D.S.; Sui, G.; Zhang, C.; Deng, Q.; Jia, L. Nanocomposite of Cu–TiO2–SiO2 with high photoactive performance for degradation of rhoda-mine B dye in aqueous wastewater. J. Nanosci. Nanotech. 2012, 12, 6265–6270. [Google Scholar] [CrossRef]
- Hu, Z.; Zhan, Y.; She, J. The role of Nd on the microstructural evolution and compressive behavior of Ti–Si alloys. Mater. Sci. Eng. A 2013, 560, 583–588. [Google Scholar] [CrossRef]
- Krämer, K.W.; Biner, D.; Frei, G.; Güdel, H.U.; Hehlen, M.P.; Lüthi, S.R. Hexagonal sodium yttrium fluoride based green and blue emitting upconversion phos-phors. Chem. Mater. 2004, 16, 1244–1251. [Google Scholar]
- Watkins, Z.; Taylor, J.; D’Souza, S.; Britton, J.; Nyokong, T. Fluorescence Behaviour and Singlet Oxygen Production of Aluminium Phthalocyanine in the Presence of Upconversion Nanoparticles. J. Fluoresc. 2015, 25, 1417–1429. [Google Scholar] [CrossRef]
- Yang, C.; Xie, H.; Li, Q.-C.; Sun, E.-J.; Su, B.-L. Adherence and interaction of cationic quantum dots on bacterial surfaces. J. Colloid Interface Sci. 2015, 450, 388–395. [Google Scholar] [CrossRef] [PubMed]
- Ryzhov, V.; Fenselau, C. Characterization of the protein subset desorbed by MALDI from whole bacterial cells. Anal. Chem. 2001, 73, 746–750. [Google Scholar] [CrossRef] [PubMed]
- Arnold, R.J.; Karty, J.A.; Ellington, A.D.; Reilly, J.P. Monitoring the growth of a bacteria culture by MALDI-MS of whole cells. Anal. Chem. 1999, 71, 1990–1996. [Google Scholar] [CrossRef] [PubMed]
- Gedda, G.; Wu, H.F. Fabrication of surface modified ZnO nanorod array for MALDI-MS analysis of bacteria in a nanoliter droplet: A multiple function biochip. Sens. Actuat. B-Chem. 2019, 288, 667–677. [Google Scholar] [CrossRef]
- Li, S.; Cui, S.; Yin, D.; Zhu, Q.; Ma, Y.; Qian, Z.; Gu, Y. Dual antibacterial activities of a chitosan-modified upconversion photodynamic therapy system against drug-resistant bacteria in deep tissue. Nanoscale 2017, 9, 3912–3924. [Google Scholar] [CrossRef]
- Luo, Z.; Zhang, L.; Zeng, R.; Tang, D. Near-infrared light-excited core–core–shell UCNP@Au@CdS upconversion nanospheres for ultrasensitive photoelectrochemical enzyme immunoassay. Anal. Chem. 2018, 90, 9568–9575. [Google Scholar] [CrossRef]
- Yin, X.; Sheng, P.; Zhong, F.; Nguyen, V.; Cai, Q.; Grimes, C. CdS/ZnIn2S4/TiO2 3D-heterostructures and their photoelectrochemical properties. New J. Chem. 2016, 40, 6675–6685. [Google Scholar] [CrossRef]
- Sheng, P.; Li, W.; Cai, J.; Wang, X.; Tong, X.; Cai, Q.; Grimes, C.A. A novel method for the preparation of a photocorrosion stable core/shell CdTe/CdS quantum dot TiO2 nanotube array photoelectrode demonstrating an AM 1.5G photoconversion efficiency of 6.12%. J. Mater. Chem. A 2013, 1, 7806–7815. [Google Scholar] [CrossRef]
- Wang, F.; Han, Y.; Lim, C.S.; Lu, Y.; Wang, J.; Xu, J.; Chen, H.; Zhang, C.; Hong, M.; Liu, X. Simultaneous phase and size control of upconversion nanocrystals through lanthanide doping. Nat. Cell Biol. 2010, 463, 1061–1065. [Google Scholar] [CrossRef]
- Su, W.; Zheng, M.; Li, L.; Wang, K.; Qiao, R.; Zhong, Y.; Hu, Y.; Li, Z. Directly coat TiO2 on hydrophobic NaYF4:Yb,Tm nanoplates and regulate their photocatalytic ac-tivities with the core size. J. Mater. Chem. A 2014, 2, 13486–13491. [Google Scholar] [CrossRef]
- Jones, J.J.; Stump, M.J.; Fleming, R.C.; Lay, J.O.; Wilkins, C.L. Investigation of MALDI-TOF and FT-MS techniques for analysis of Escherichia coli whole cells. Anal. Chem. 2003, 75, 1340–1347. [Google Scholar] [CrossRef] [PubMed]
- Russell, S.C.; Edwards, N.; Fenselau, C. Detection of plasmid insertion in Escherichia coli by MALDI-TOF mass spectrometry. Anal. Chem. 2007, 79, 5399–5406. [Google Scholar] [CrossRef] [PubMed]
- Sutherland, J.B.; Heinze, T.M.; Holder, C.L.; Voorhees, K.J.; Lay, J.O., Jr. Identification of bacterial proteins observed in MALDI TOF mass spectra from whole cells. Anal. Chem. 1999, 71, 3226–3230. [Google Scholar]
Publisher’s Note: MDPI stays neutral with regard to jurisdictional claims in published maps and institutional affiliations. |
© 2021 by the authors. Licensee MDPI, Basel, Switzerland. This article is an open access article distributed under the terms and conditions of the Creative Commons Attribution (CC BY) license (http://creativecommons.org/licenses/by/4.0/).